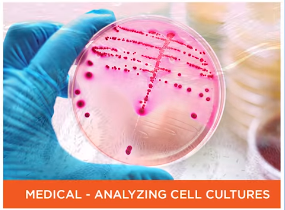

图像传感器主要有两种: CCD 、 CMOS
应用的需求决定了芯片类型的选择。
一、优点
高帧率
高分辨率
低功耗
改善的噪声性能
提高的量子效率
高动态范围
高性价比
低散热 (在不进行散热时也能长时间运行可以方便携带),在一些噪声敏感、和自动装置中很有好处。
-----------------------------------------------------------------------------------------------------------------------------------------
动态范围对图像的影响

交通监控通常需要高动态范围传感器
----------------------------------------------------------------------------------------------------------------------------------------
二、应用
1、细胞培养的自动扫描分析

本文介绍了CMOS图像传感器相对于CCD的优势,如高帧率、高分辨率、低功耗和低噪声性能,并强调了其在高动态范围和性价比方面的提升。CMOS传感器的应用广泛,包括细胞培养分析、食品质量检测、瓶装检测和高速检测等场景,尤其在需要低噪声和低成本的领域展现出优越性。
本文介绍了CMOS图像传感器相对于CCD的优势,如高帧率、高分辨率、低功耗和低噪声性能,并强调了其在高动态范围和性价比方面的提升。CMOS传感器的应用广泛,包括细胞培养分析、食品质量检测、瓶装检测和高速检测等场景,尤其在需要低噪声和低成本的领域展现出优越性。
 最低0.47元/天 解锁文章
最低0.47元/天 解锁文章


















 6799
6799

 被折叠的 条评论
为什么被折叠?
被折叠的 条评论
为什么被折叠?










